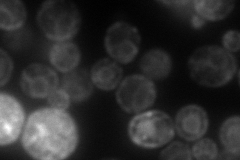
YAR033W
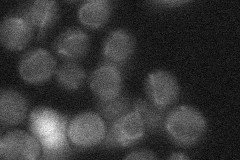
YAR033W
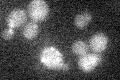
YAR033W

View description
Putative integral membrane protein, involved in vesicle formation; forms complex with Mst27p; member of DUP240 gene family; binds COPI and COPII vesicles
Localization:
Intensity:
Fold change:
Significance:
-
C’ GFP library in SD

below threshold13.89 -
N' NOP1pr-GFP in SD

ER79.9209 -
N' TEF2pr-mCherry in SD
ER131.838 -
N' NATIVEpr-GFP in SD
below threshold17.6342 -
N' TEF2pr-VC and Cyto-VN in SD

ER,punctate36.2688 -
C’ GFP library in SD+DTT

cytosol15.591.12No -
C’ GFP library in SD+H2O2
cytosol13.140.94No -
C’ GFP library in Starvation Media

cytosol20.941.5No -
C’ GFP library on the background of Pup2-DaMP

below threshold -
C’ GFP library on the background of CCT mutant

below threshold13.73250.988122No
